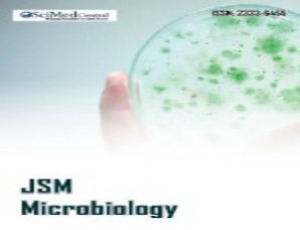
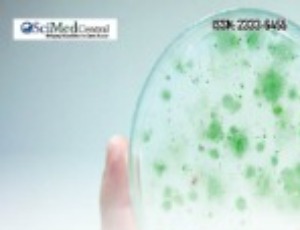

-
Open Access: Creative Commons
-
Review Process: Double Blind
-
Online ISSN: 2333-6455
-
JsciMed Central Publisher Id (DOI): 10.47739
-
Article Formats Available: PDF, Fulltext, XML, ePub
-
Submit Manuscript
-
Email
-
DOI: https://doi.org/10.47739/2333-6455/
-
Telephone: 302-261-5000
-
For Journal related queries: Journal mail id
-
For APC queries: accounts@jscimedcentral.com
-
For Other queries: info@jscimedcentral.com
-
Telephone (Whatsapp): 302-261-5000